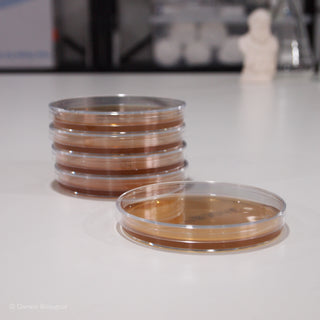

I was a little worried when the lungs came as flat as pancakes as we had had some from another supplier which were vacuum packed and this had damaged the integrity of the lungs so that they wouldn't blow up. Yours however were fine. The teachers were impressed at how fresh they seemed and commented on how much they liked them.
However when we buy lungs straight from the abattoir we do not have to pay VAT but we do to you. Why is this ?
This took a little longer to come than the other products we purchased ,but it was very healthy and worked well in the bubbling experiment.